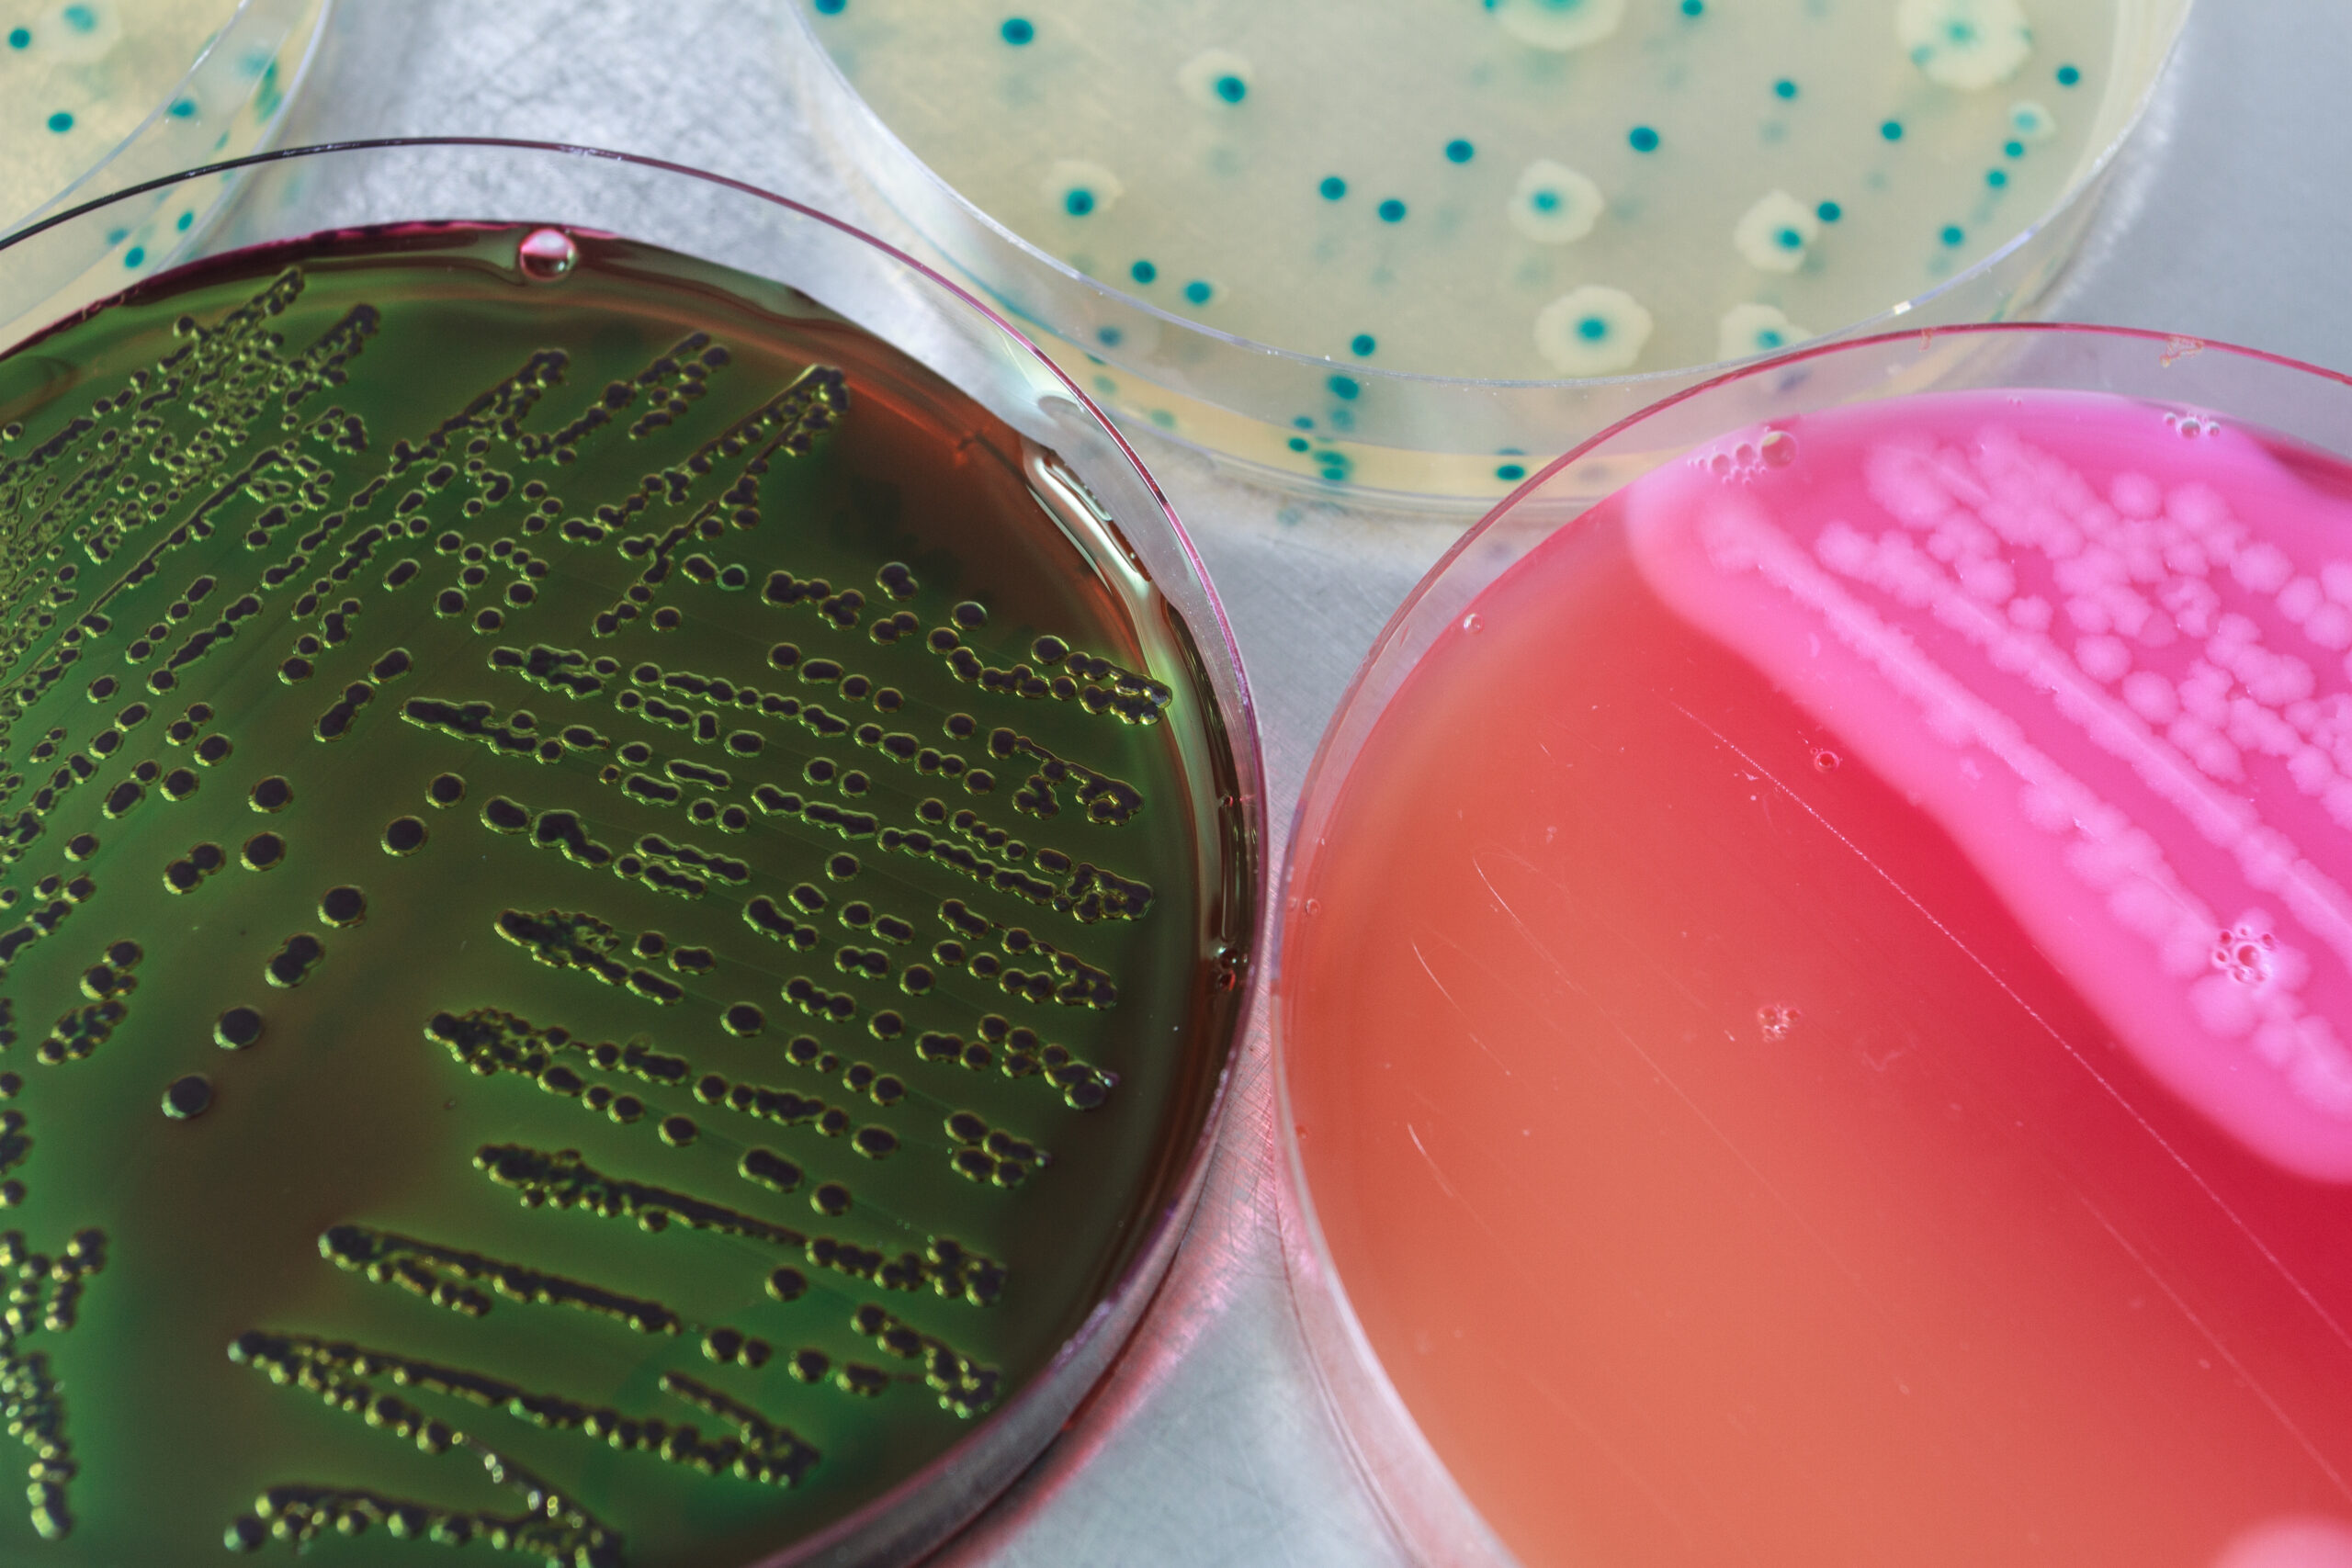

Especialista de la UACh se refiere a alerta sanitaria de Listeria monocytogenes en alimentos
A propósito de los casos de alertas alimentarias relacionados con Listeria monocytogenes, el Dr. Aníbal Concha Meyer, académico del Instituto de Ciencia y Tecnología de los Alimentos (ICYTAL) de la Universidad Austral de Chile, especialista en este tema, explicó que se trata de una bacteria que puede causar graves problemas de salud en la población. …
Read More